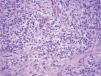

Paciente de 19 años con antecedentes personales de diabetes mellitus tipo 1 y candidiasis vulvo-vaginal de repetición. Acude a nuestras consultas refiriendo prurito vulvar de más de un año de evolución, que se había intensificado llegando incluso a producir sensación de dolor.
Exploración físicaA la exploración física encontramos pápulas eritematosas de superficie lisa, alguna levemente erosionada, de bordes bien delimitados, no infiltradas, con un tamaño entre 4-5mm, en la cara interna de los labios mayores (fig. 1). Se observaba, además, abundante flujo blanquecino no maloliente.
Exploraciones complementariasRealizamos diversas pruebas complementarias: serologías, que resultaron negativas para el virus de la inmunodeficiencia humana, el virus de la hepatitis C, el virus de la hepatitis B y lúes, cultivo del flujo vaginal, positivo para Candida albicans, y biopsia de una de las lesiones. La histología mostraba piel del área genital con erosión superficial ocupada por depósitos de fibrina, intensos cambios regenerativos en los bordes y denso infiltrado en banda, localizado en la dermis superior (fig. 2), compuesto en su gran mayoría por células plasmáticas (fig. 3), sin otros cambios aparentes. Sobre la muestra de biopsia se realizaron técnicas de inmunohistoquímica que no detectaron treponemas.
¿Cuál es su diagnóstico?
DiagnósticoCon estos datos llegamos al diagnóstico de vulvitis de Zoon o vulvitis de células plasmáticas.
Evolución y tratamientoRealizamos tratamiento para la candidiasis con ciclos de fluconazol oral, con el que se consiguió la resolución de ambos cuadros.
ComentarioLa vulvitis de Zoon o vulvitis de células plasmáticas es una patología infrecuente (menos de 40 casos descritos en la literatura) y de etiología desconocida, aunque se han propuesto diversas teorías etiopatogénicas (vírica1,2, autoinmune3, hormonal e irritativa). Su patogenia resulta incierta, aunque muchos autores coinciden en describirla como una respuesta inflamatoria inespecífica a un factor exógeno no determinado, asociada a diversos factores favorecedores: escasa higiene, calor y sudor excesivos, traumatismos y fricción continuada.
La clínica consiste en lesiones en la mucosa vulvar tipo pápulas eritematosas brillantes con matiz anaranjado, en ocasiones erosionadas, bien definidas, habitualmente en labios menores, mucosa periuretral y menos frecuentemente en labios mayores; en ocasiones asocian pápulas purpúricas descritas como «en grano de cayena».
La sintomatología es diversa, con prurito, escozor, dolor e incluso dispareunia, y han sido descritos casos asintomáticos. Es importante destacar que su curso es generalmente crónico y sin progresión a malignidad.
Dado que los datos clínicos pueden ser bastante inespecíficos, su diagnóstico diferencial es amplio: liquen plano, liquen escleroso, pénfigo vulgar, dermatitis de contacto, infecciones como lúes o herpes simple, distintas neoplasias, y otras causas como traumatismos, dermatitis de Jacquet (granuloma glúteo infantil), etc.
El estudio histológico es imprescindible para su diagnóstico y permite descartar otras patologías, principalmente aquellas con características de malignidad. Los principales datos histológicos son: presencia de un denso infiltrado dérmico en banda compuesto en su mayoría por células plasmáticas (mayor al 50 % según algunos autores)4, y otros posibles rasgos como atrofia epidérmica con presencia de queratinocitos alargados (descritos como en diamante), proliferación vascular con extravasación de eritrocitos, depósitos de hemosiderina y ausencia de atipia o mitosis. Es una enfermedad de curso con frecuencia crónico y resistente a diversos tratamientos; han sido utilizados corticoides1,2, estrógenos, antifúngicos5, etretinato4, ciclosporina tópica, antibióticos, misoprostol tópico, crioterapia, bloqueo neurológico, interferón (INF)2, ablación con láser, imiquimod1 y cirugía, ninguno de ellos con una eficacia probada. Nuestra paciente obtuvo una resolución completa tras recibir tratamiento para su candidiasis, lo que nosotros consideramos un factor favorecedor debido a la irritación y el rascado consecuente al prurito mantenido.
Han sido descritos casos con lesiones clínica e histológicamente idénticas a este cuadro, pero de localización extragenital, principalmente en labios, encías, paladar, lengua, epiglotis, laringe6 y conjuntiva, que se han relacionado con respuesta a traumas mecánicos, daño actínico o sensibilización por contacto a goma de mascar, pastas de dientes, menta, etc.
Se utiliza el término mucositis de células plasmáticas para englobar esta entidad tanto en el aspecto clínico como en el histopatológico6.
Conflicto de intereses
Declaramos no tener ningún conflicto de intereses.